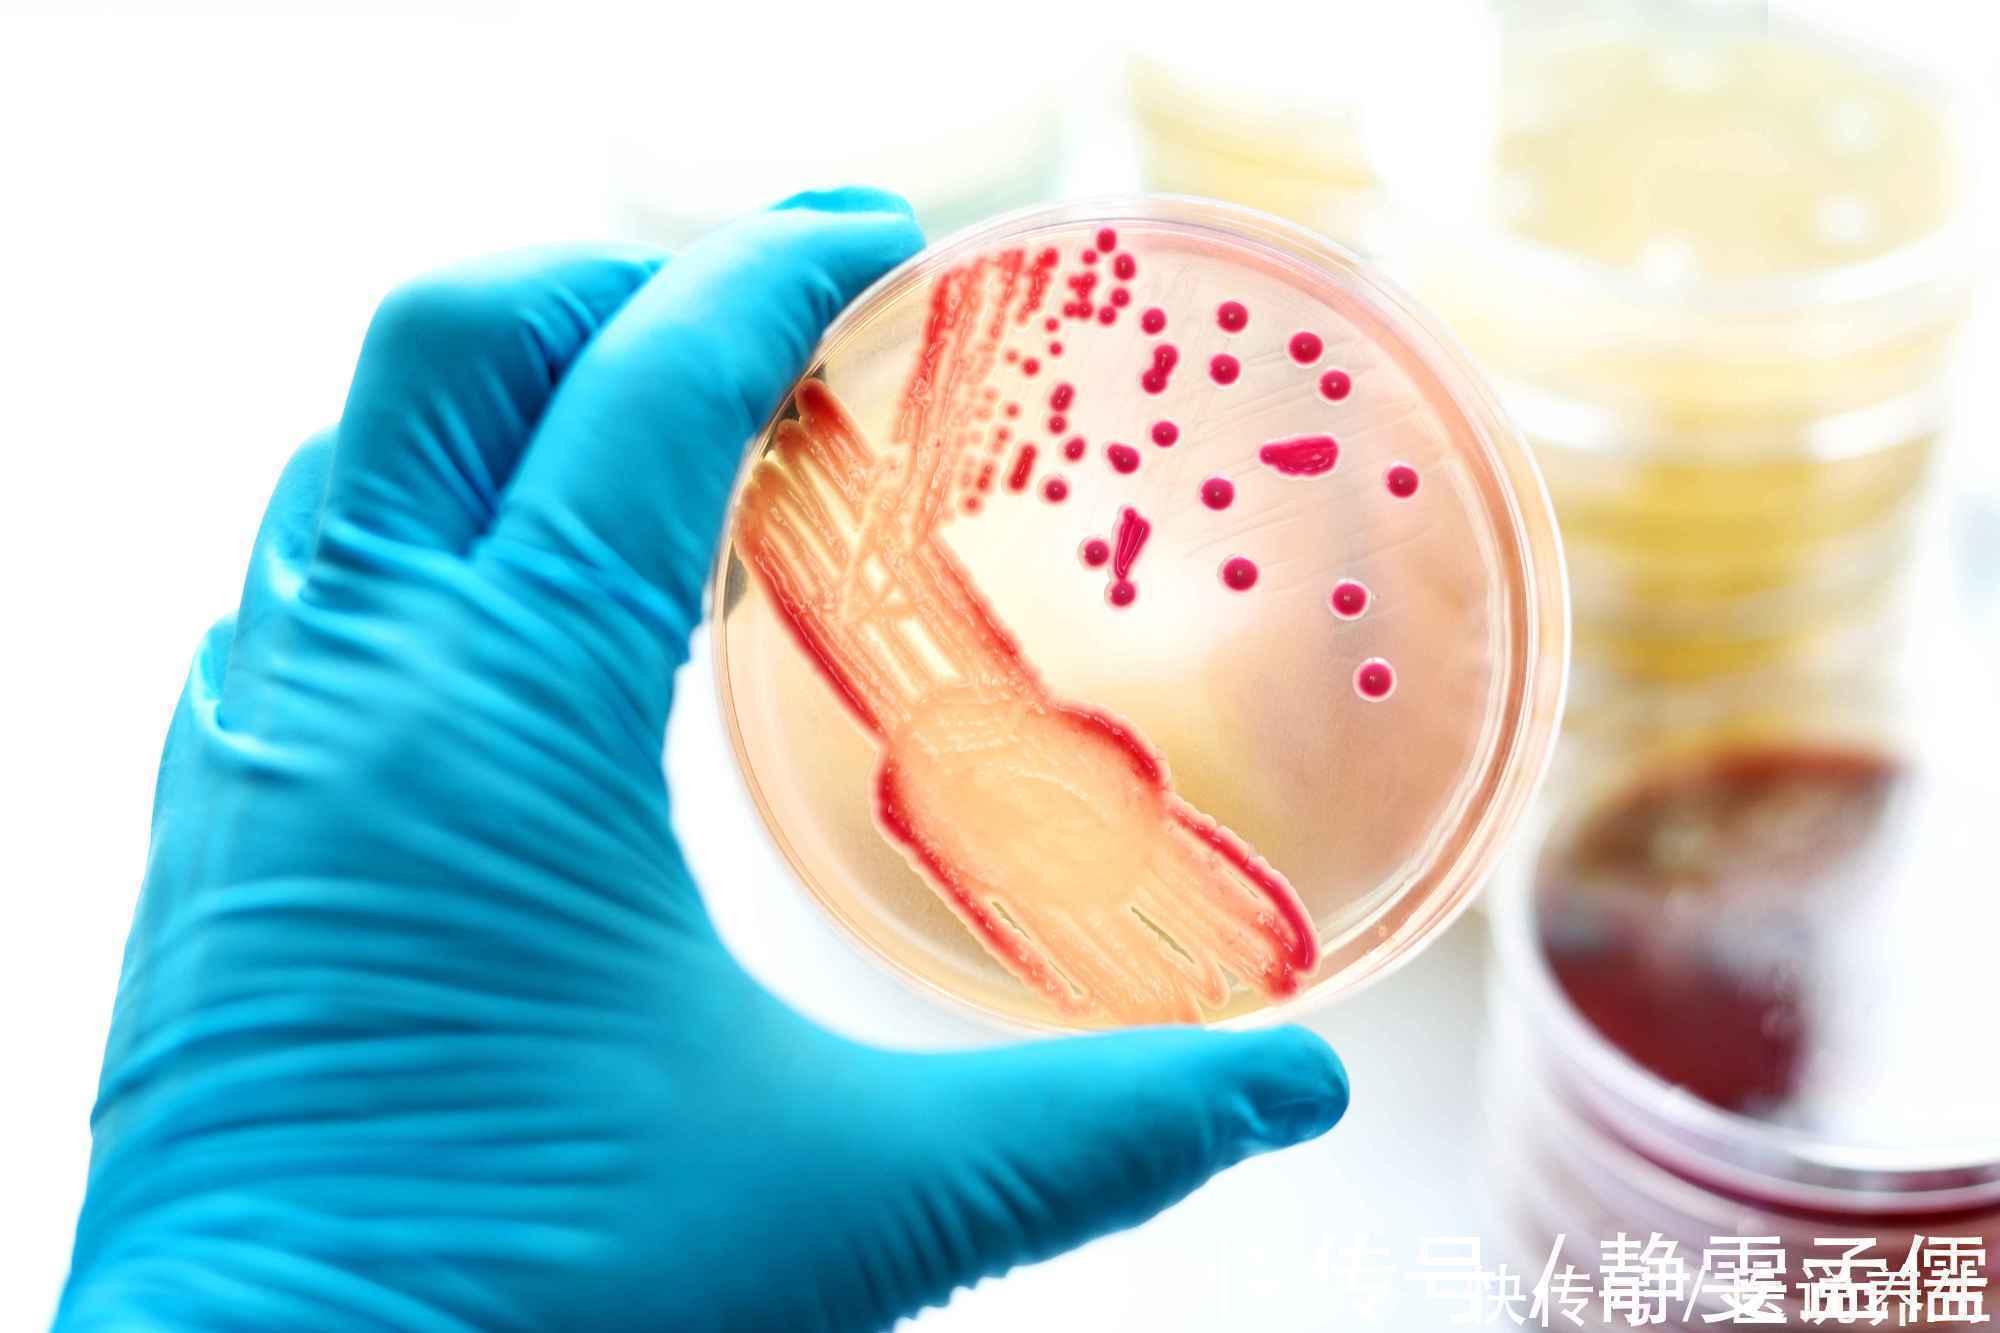
家里不起眼的地方，竟是霉菌藏身地，不想得病，劝你勤快点

家里不起眼的地方,竟是霉菌藏身地,不想得病,劝你勤快点
有一种真菌藏身在我们家中一些温暖又潮湿的地方,它就是霉菌。霉菌主要是以寄生以及腐生的方式生存,如果人体被感染,危害极大。那么感染霉菌会为人体带来哪些危害?家里哪些不起眼地方是霉菌的藏身地?怎么清洁这些地方?别着急,通过本文相信大家会得到初步的答案。

文章插图
霉菌属真菌中的一种,世界卫生组织曾公布调查结果,霉菌以不同的形式存在全世界各国80%以上的家庭中,我国因环境污染因素而使霉菌分布的情况更加严重。人若不慎长期吸入霉菌,会引起呼吸道不适或发生过敏,诱发扁桃体炎、支气管炎、哮喘等。免疫力差的人甚至会因长期吸入霉菌而出现头痛、发烧、中毒等现象。霉菌中的黄曲霉素,已经被世界卫生组织列入为一等致癌物,毒性比砒霜高68倍。
文章插图
家里四个不起眼地方是霉菌的藏身地。
第一,冰箱门。冰箱门里的密封条,可以使冰箱拥有更好的制冷效果,但是这些塑料的密封条以及乳胶非常容易滋生霉菌。如果冰箱内的食物受到霉菌感染后进入到我们身体就会产生一系列的疾病,因此一定要对冰箱门进行及时的清洗。
清洗冰箱门,我们可以使用可乐和酒精。将可乐和酒精按照1:1的分量进行搅拌,用纱布或者纸巾缠绕在叉子上并在冰箱门缝中擦拭,建议每周清洗一到两次。

文章插图
第二,卫生间。卫生间是我们家中最常用到水的区域,同时洗澡的时候也会用到热水,高温高湿的环境很适合霉菌滋生,特别是在墙角、水龙头、瓷砖缝和浴室帘子等地方。因此,我们在使用完卫生间之后要把排气扇打开、敞开门口、拉开浴帘,这样才能有效地控制卫生间的湿度和温度。
对于卫生间内的霉菌,我们可以把纸巾泡在用漂白剂和水按照1:10比例形成的溶液中,待完全浸湿后贴在霉菌生长地方大于30分钟,然后使用刷子清洗干净即可。
【家里不起眼的地方,竟是霉菌藏身地,不想得病,劝你勤快点】

文章插图
第三,洗衣机。洗衣机储存着我们需要换洗的衣物,存放时间由几个小时至几天不等,在这段时间内非常容易滋生霉菌,从而诱发霉菌性炎症、慢性荨麻疹等疾病。
我们可以把一条毛巾浸泡在里面200毫升白醋中,把带有白醋的毛巾放到洗衣机内甩干,等待一小时后倒入60度热水进洗衣机,运转15分钟后再清洗干净即可。

文章插图
第四,阳台。很多人会在阳台里使用腐殖土种植很多植物,然而这种土壤内会产生大量的霉菌,分布在阳台的瓷砖、地面、窗台等地方。
清洗阳台,我们可以用洗洁精、肥皂等,清洗完成后用抹布、拖把擦干即可。

文章插图
综上所述,这四个地方是我们家中容易滋生霉菌的地方,为了避免霉菌对人体可能产生的四种危害,我们必须要勤快清洁。除了对家居环境的清洁之外,我们还必须注意好个人的卫生以及不要使用发霉的食物,防止霉菌毒素破坏健康。
特别声明:本站内容均来自网友提供或互联网,仅供参考,请勿用于商业和其他非法用途。如果侵犯了您的权益请与我们联系,我们将在24小时内删除。
